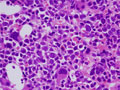

- 1.Bone marrow / Hematopoietic system
- š(4) Myelodysplastic syndrome (MDS)
Microscopic image (H&E intermediate power view): The marrow of MDS is hypercellular by excessive blasts with disordered differentiation in varying degrees. This picture represents as gMDS, an increased risk of progression to AMLh by WHO classification. It is also categorized as RAEBt according to FAB classification. Dysplastic differentiation is found in many lineages other than myeloblastes. There is a marked increase in the number of megakaryocytes with irregular shape of nuclei in this picture.
Click the image to see the enlarged image.